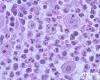
HSXB2197 ISK （<em>Ishikawa</em>）,<em>人子</em><em>宫内</em>膜癌细胞

Ishikawa 细胞,Ishikawa人子宫内膜癌细胞
- 产地:国外
- 供应商:上海栩冉生物科技有限公司
- 供应商报价:面议
- 标签:Ishikawa 细胞,Ishikawa人子宫内膜癌细胞,-1,上海栩冉生物科技有限公司
上海栩冉生物科技有限公司
我公司——依托复旦大学,集研发、销售、实验室技术服务于一体的高科技企业。 专业经营进口胎牛血清、细胞因子、elisa试剂盒等实验室试剂、化工产品、实验室消耗品、实验室耗材以及实验室器材。产品涉及分子生物学、细胞生物学、细菌学、遗传学、免疫学、生物化学、蛋白质学、细胞***、临床应用等领域。 主要产品及服务: 血清 细胞 抗体 细胞因子 试剂盒 实验试剂 实验耗材 技术服务 实验仪器
实验技术服务内容。欢迎广大师生选购。:李
关键词:Ishikawa 细胞,Ishikawa人子宫内膜癌细胞
简介:全国统一价格,全国各地均可发货,远到香港、澳门、福建、新疆、内蒙古等地:
产品名称:Ishikawa 细胞,Ishikawa人子宫内膜癌细胞
库存状态:现货
细胞规格:株
质控标准:无支原体、无污染、符合标准
运输方式:新鲜运输和冻存管运输
货期:新鲜运输需要1-2周,冻存管运输的需要2-3天
污染的种类可分成细菌、酵母菌、霉菌、病毒和霉浆菌。主要的污染原因为无菌操作技术不当、操作室 环境不佳、污染之血清和污染之细胞等。严格之无菌操作技术、清洁的环境、与品质良好之细胞来源和培养 基配制是减低污染之Z好方法。2.如果细胞发生微生物污染时,应如何处理?直接灭菌后丢弃之。3.购买之细胞冷冻管经解冻后,为何会发生细胞数目太少之情形? 研究人员在冷冻细胞之培养时出现细胞数目太少, 大都是因为离心过程操作上的失误,造成细胞的物理性 损伤, 以及细胞流失。建议细胞解冻后不要立刻离心,应待细胞生长隔夜后再更换培养基即可。4.购买之细胞死亡或细胞存活率不佳可能原因? 研究人员在细胞培养时出现存活率不佳, 常见原因可归纳为:培养基使用错误或培养基品质不佳。血清使用 错误或血清的品质不佳。解冻过程错误。冷冻细胞解冻后,加以洗涤细胞和离心。悬浮细胞误认为死细胞。培养温度使用错误。细胞置于-80℃太久。5.收到之冷冻管瓶身破裂,瓶盖有裂纹,或瓶盖脱落之原因? 冷冻管瓶盖裂纹,或瓶身破裂,可能是因为操作者夹取冷冻管时用力不当,造成冷冻管裂损,建议使用止血 钳小心夹取。另冷冻管瓶盖松动或松脱,乃因热胀冷缩之物理现象,冷冻管有可能因此而造成细胞污染,故冷冻管于放入和取出液氮桶时,均应立刻将冷冻管再一次扭紧。
相关推荐:
Gibco 12657-029胎牛血清500ML 2016 推荐(热卖)
Gibco30044-033 ES级别胎牛血清500ML
Gibco 12664025间充质干细胞胎牛血清500ML 5586
Gibco 16250078超低IgG胎牛血清500ML 6140
Gibco10099-141优级胎牛血清500ML 5168
Gibco16000-044特级胎牛血清(美国源)500ML
Gibco C2027050乌拉圭胎牛血清500ML 2016 南美 更高性价比胎牛血清,适合一般细胞的培养
Gibco 12676-029热灭活活性炭处理的胎牛血清500ML 8000
Gibco10100-147热灭活胎牛血清500ML 6321
Gibco 16141-079胚胎干细胞专用胎牛血清500ML 5880
Hyclone南美普通胎牛血清Sv30087.01100ML 396
Hyclone南美普通胎牛血清Sv30087.02500ML 1680 推荐(热卖)常年备库存!!
HycloneSH30070.03E胚胎干细胞专用胎牛血清500ML
Hyclone SH30070.03 特级胎牛血清500ML
Hyclone 加拿大优等SH30396.03胎牛血清500ML
Hyclone SH30079.03 透析性胎牛血清500ML
Hyclone活性炭/葡聚糖处理胎牛血清SH30068.03500ML
Hyclone SH30084.03澳洲优等胎牛血清500ML 3179
Hyclone SH30084.03IR优等澳大利亚胎牛血清|照射胎牛血清 500ML 3399
Hyclone SH30084.03IH澳大利亚优级3x100nm过滤 辐射和热灭活胎牛血清 500ML 3476
Hyclone SH30084.03HI 澳大利亚优级3x100nm过滤 辐射和热灭活胎牛血清 500ML3256
Hyclone SH30070.03T 四环素筛选专用特级胎牛血清500ML
Hyclone SH30414.03 新西兰补铁小牛血清1000ML 990
Hyclone SH30541.03 促生长型牛血清
PAA15-101普通胎牛血清500ML 3150
PAA15-151优级胎牛血清500ML 4750
clontech 631101四环素胎牛血清500ML 4705
clontech 631158ES级别胎牛血清500ML 4705
Biochrom S0113/S0613特级胎牛血清100ML 800
Biochrom S0115/S0615特级胎牛血清500ML 2900
Biochrom S3113活性炭过滤胎牛血清100ML 1900
Biochrom S3115 活性炭过滤胎牛血清500ML 6750
Biochrom 胚胎干细胞专用胎牛血清100ML 1200
Biochrom 胚胎干细胞专用胎牛血清500ML 4500
我司栩冉生物热推细胞产品:
Ⅱ型肺泡上皮细胞 | ATCC/ScienCell/中科院/复旦大学/国内构建 |
ATCC菌种 | ATCC/ScienCell/中科院/复旦大学/国内构建 |
ATCC菌株 | ATCC/ScienCell/中科院/复旦大学/国内构建 |
II型肺泡上皮细胞 | ATCC/ScienCell/中科院/复旦大学/国内构建 |
T细胞白血病细胞 | ATCC/ScienCell/中科院/复旦大学/国内构建 |
白耗牛皮肤细胞 | ATCC/ScienCell/中科院/复旦大学/国内构建 |
成骨细胞 | ATCC/ScienCell/中科院/复旦大学/国内构建 |
成人表皮角化细胞 | ATCC/ScienCell/中科院/复旦大学/国内构建 |
成纤维细胞 | ATCC/ScienCell/中科院/复旦大学/国内构建 |
大脑皮层神经元 | ATCC/ScienCell/中科院/复旦大学/国内构建 |
大鼠Ⅱ型肺泡上皮细胞 | ATCC/ScienCell/中科院/复旦大学/国内构建 |
大鼠肠动脉内皮细胞 | ATCC/ScienCell/中科院/复旦大学/国内构建 |
大鼠肺成纤维细胞 | ATCC/ScienCell/中科院/复旦大学/国内构建 |
大鼠肺泡上皮细胞 | ATCC/ScienCell/中科院/复旦大学/国内构建 |
大鼠肺微血管内皮细胞 | ATCC/ScienCell/中科院/复旦大学/国内构建 |
大鼠肝癌细胞 | ATCC/ScienCell/中科院/复旦大学/国内构建 |
大鼠肝窦内皮细胞 | ATCC/ScienCell/中科院/复旦大学/国内构建 |
大鼠肝细胞 | ATCC/ScienCell/中科院/复旦大学/国内构建 |
大鼠肝星形细胞 | ATCC/ScienCell/中科院/复旦大学/国内构建 |
大鼠骨骼肌细胞 | ATCC/ScienCell/中科院/复旦大学/国内构建 |
大鼠间充质干细胞 | ATCC/ScienCell/中科院/复旦大学/国内构建 |
大鼠海马神经元细胞 | ATCC/ScienCell/中科院/复旦大学/国内构建 |
大鼠颌下腺上皮细胞 | ATCC/ScienCell/中科院/复旦大学/国内构建 |
大鼠间质干细胞 | ATCC/ScienCell/中科院/复旦大学/国内构建 |
大鼠角膜内皮细胞 | ATCC/ScienCell/中科院/复旦大学/国内构建 |
大鼠巨噬细胞 | ATCC/ScienCell/中科院/复旦大学/国内构建 |
大鼠卵巢颗粒细胞 | ATCC/ScienCell/中科院/复旦大学/国内构建 |
大鼠脑动脉血管平滑肌细胞 | ATCC/ScienCell/中科院/复旦大学/国内构建 |
大鼠脑微血管内皮细胞 | ATCC/ScienCell/中科院/复旦大学/国内构建 |
大鼠内皮祖细胞 | ATCC/ScienCell/中科院/复旦大学/国内构建 |
大鼠气道平滑肌细胞 | ATCC/ScienCell/中科院/复旦大学/国内构建 |
大鼠前脂肪细胞 | ATCC/ScienCell/中科院/复旦大学/国内构建 |
大鼠肾小管上皮细胞 | ATCC/ScienCell/中科院/复旦大学/国内构建 |
大鼠视网膜色素上皮细胞 | ATCC/ScienCell/中科院/复旦大学/国内构建 |
大鼠视网膜微血管内皮细胞 | ATCC/ScienCell/中科院/复旦大学/国内构建 |
大鼠树突状细胞 | ATCC/ScienCell/中科院/复旦大学/国内构建 |
大鼠心肌成纤维细胞 | ATCC/ScienCell/中科院/复旦大学/国内构建 |
大鼠导管上皮细胞 | ATCC/ScienCell/中科院/复旦大学/国内构建 |
大鼠星状细胞 | ATCC/ScienCell/中科院/复旦大学/国内构建 |
大鼠主动脉内皮细胞 | ATCC/ScienCell/中科院/复旦大学/国内构建 |
发绿色荧光的小鼠胚胎干细胞 | ATCC/ScienCell/中科院/复旦大学/国内构建 |
非何杰金氏淋巴瘤细胞 | ATCC/ScienCell/中科院/复旦大学/国内构建 |
非小细胞肺癌 | ATCC/ScienCell/中科院/复旦大学/国内构建 |
非洲绿猴肾细胞 | ATCC/ScienCell/中科院/复旦大学/国内构建 |
非洲绿猴肾细胞系 | ATCC/ScienCell/中科院/复旦大学/国内构建 |
肺癌细胞(淋巴结转移) | ATCC/ScienCell/中科院/复旦大学/国内构建 |
肺成纤维细胞 | ATCC/ScienCell/中科院/复旦大学/国内构建 |
肺微血管内皮细胞 | ATCC/ScienCell/中科院/复旦大学/国内构建 |
肺血管平滑肌细胞 | ATCC/ScienCell/中科院/复旦大学/国内构建 |
肝癌细胞系 | ATCC/ScienCell/中科院/复旦大学/国内构建 |
肝癌组织细胞 | ATCC/ScienCell/中科院/复旦大学/国内构建 |
肝窦内皮细胞 | ATCC/ScienCell/中科院/复旦大学/国内构建 |
肝内胆管上皮细胞 | ATCC/ScienCell/中科院/复旦大学/国内构建 |
肝实质细胞 | ATCC/ScienCell/中科院/复旦大学/国内构建 |
高转移潜能肝癌细胞 | ATCC/ScienCell/中科院/复旦大学/国内构建 |
宫颈癌细胞 | ATCC/ScienCell/中科院/复旦大学/国内构建 |
骨骼肌细胞 | ATCC/ScienCell/中科院/复旦大学/国内构建 |
瘤细胞 | ATCC/ScienCell/中科院/复旦大学/国内构建 |
骨细胞 | ATCC/ScienCell/中科院/复旦大学/国内构建 |
关节炎滑膜成纤维细胞 | ATCC/ScienCell/中科院/复旦大学/国内构建 |
冠状动脉内皮细胞 | ATCC/ScienCell/中科院/复旦大学/国内构建 |
海马神经元细胞 | ATCC/ScienCell/中科院/复旦大学/国内构建 |
滑膜成纤维细胞 | ATCC/ScienCell/中科院/复旦大学/国内构建 |
滑膜细胞 | ATCC/ScienCell/中科院/复旦大学/国内构建 |
鸡胚成纤维细胞 | ATCC/ScienCell/中科院/复旦大学/国内构建 |
畸胎瘤细胞 | ATCC/ScienCell/中科院/复旦大学/国内构建 |
甲状腺滤泡上皮细胞 | ATCC/ScienCell/中科院/复旦大学/国内构建 |
间充质干细胞 | ATCC/ScienCell/中科院/复旦大学/国内构建 |
角膜内皮细胞 | ATCC/ScienCell/中科院/复旦大学/国内构建 |
角膜上皮细胞 | ATCC/ScienCell/中科院/复旦大学/国内构建 |
角质形成细胞 | ATCC/ScienCell/中科院/复旦大学/国内构建 |
结肠癌细胞 | ATCC/ScienCell/中科院/复旦大学/国内构建 |
结直肠癌细胞 | ATCC/ScienCell/中科院/复旦大学/国内构建 |
晶状体上皮细胞 | ATCC/ScienCell/中科院/复旦大学/国内构建 |
口腔粘膜上皮细胞 | ATCC/ScienCell/中科院/复旦大学/国内构建 |
淋巴成纤维细胞 | ATCC/ScienCell/中科院/复旦大学/国内构建 |
淋巴管内皮细胞 | ATCC/ScienCell/中科院/复旦大学/国内构建 |
淋巴瘤细胞 | ATCC/ScienCell/中科院/复旦大学/国内构建 |
卵巢癌细胞 | ATCC/ScienCell/中科院/复旦大学/国内构建 |
卵巢颗粒细胞 | ATCC/ScienCell/中科院/复旦大学/国内构建 |
绿猴肾细胞 | ATCC/ScienCell/中科院/复旦大学/国内构建 |
慢性粒细胞白血病细胞 | ATCC/ScienCell/中科院/复旦大学/国内构建 |
猫肾细胞 | ATCC/ScienCell/中科院/复旦大学/国内构建 |
毛囊角质细胞 | ATCC/ScienCell/中科院/复旦大学/国内构建 |
脑微血管内皮细胞 | ATCC/ScienCell/中科院/复旦大学/国内构建 |
内脏脂肪细胞 | ATCC/ScienCell/中科院/复旦大学/国内构建 |
胚胎大鼠主动脉平滑肌细胞 | ATCC/ScienCell/中科院/复旦大学/国内构建 |
皮肤成纤维细胞 | ATCC/ScienCell/中科院/复旦大学/国内构建 |
皮下脂肪细胞 | ATCC/ScienCell/中科院/复旦大学/国内构建 |
破骨细胞 | ATCC/ScienCell/中科院/复旦大学/国内构建 |
脐动脉内皮细胞 | ATCC/ScienCell/中科院/复旦大学/国内构建 |
脐动脉平滑肌细胞 | ATCC/ScienCell/中科院/复旦大学/国内构建 |
脐静脉内皮细胞 | ATCC/ScienCell/中科院/复旦大学/国内构建 |
气道平滑肌细胞 | ATCC/ScienCell/中科院/复旦大学/国内构建 |
前列腺上皮细胞 | ATCC/ScienCell/中科院/复旦大学/国内构建 |
前脂肪细胞 | ATCC/ScienCell/中科院/复旦大学/国内构建 |
人B淋巴细胞 | ATCC/ScienCell/中科院/复旦大学/国内构建 |
人T淋巴细胞 | ATCC/ScienCell/中科院/复旦大学/国内构建 |
人白血病阿霉素耐药株 | ATCC/ScienCell/中科院/复旦大学/国内构建 |
人鼻咽癌细胞 | ATCC/ScienCell/中科院/复旦大学/国内构建 |
人鼻咽癌细胞系 | ATCC/ScienCell/中科院/复旦大学/国内构建 |
人伯基特淋巴瘤细胞 | ATCC/ScienCell/中科院/复旦大学/国内构建 |
人肠上皮细胞 | ATCC/ScienCell/中科院/复旦大学/国内构建 |
人成纤维样滑膜细胞 | ATCC/ScienCell/中科院/复旦大学/国内构建 |
人大肠癌细胞 | ATCC/ScienCell/中科院/复旦大学/国内构建 |
人胆管癌细胞 | ATCC/ScienCell/中科院/复旦大学/国内构建 |
人非小细胞肺癌腺癌细胞 | ATCC/ScienCell/中科院/复旦大学/国内构建 |
人肺癌细胞 | ATCC/ScienCell/中科院/复旦大学/国内构建 |
人肺癌细胞株 | ATCC/ScienCell/中科院/复旦大学/国内构建 |
人肺动脉内皮细胞 | ATCC/ScienCell/中科院/复旦大学/国内构建 |
人肺鳞癌细胞 | ATCC/ScienCell/中科院/复旦大学/国内构建 |
人肺腺癌耐药细胞株 | ATCC/ScienCell/中科院/复旦大学/国内构建 |
人肺腺癌细胞 | ATCC/ScienCell/中科院/复旦大学/国内构建 |
人肺腺癌细胞培美曲塞耐药株 | ATCC/ScienCell/中科院/复旦大学/国内构建 |
人腹膜毛细血管内皮细胞 | ATCC/ScienCell/中科院/复旦大学/国内构建 |
人肝癌细胞株 | ATCC/ScienCell/中科院/复旦大学/国内构建 |
人肝窦内皮细胞 | ATCC/ScienCell/中科院/复旦大学/国内构建 |
人肝腹水腺癌细胞 | ATCC/ScienCell/中科院/复旦大学/国内构建 |
人肝内胆管上皮细胞 | ATCC/ScienCell/中科院/复旦大学/国内构建 |
人宫颈癌细胞 | ATCC/ScienCell/中科院/复旦大学/国内构建 |
人宫颈鳞状细胞癌 | ATCC/ScienCell/中科院/复旦大学/国内构建 |
人关节炎滑膜成纤维细胞 | ATCC/ScienCell/中科院/复旦大学/国内构建 |
人海马神经元细胞 | ATCC/ScienCell/中科院/复旦大学/国内构建 |
人急性淋巴细胞白血病细胞 | ATCC/ScienCell/中科院/复旦大学/国内构建 |
人急性髓系细胞白血病细胞 | ATCC/ScienCell/中科院/复旦大学/国内构建 |
人急性早幼粒细胞白血病细胞 | ATCC/ScienCell/中科院/复旦大学/国内构建 |
人甲状腺癌细胞 | ATCC/ScienCell/中科院/复旦大学/国内构建 |
人甲状腺滤泡上皮细胞 | ATCC/ScienCell/中科院/复旦大学/国内构建 |
人胶质瘤细胞 | ATCC/ScienCell/中科院/复旦大学/国内构建 |
人胶质母细胞瘤 | ATCC/ScienCell/中科院/复旦大学/国内构建 |
人角膜成纤维细胞 | ATCC/ScienCell/中科院/复旦大学/国内构建 |
人角膜内皮细胞 | ATCC/ScienCell/中科院/复旦大学/国内构建 |
人角膜上皮细胞 | ATCC/ScienCell/中科院/复旦大学/国内构建 |
人结肠癌细胞 | ATCC/ScienCell/中科院/复旦大学/国内构建 |
人结肠腺癌细胞 | ATCC/ScienCell/中科院/复旦大学/国内构建 |
人结直肠癌细胞 | ATCC/ScienCell/中科院/复旦大学/国内构建 |
人晶状体上皮细胞 | ATCC/ScienCell/中科院/复旦大学/国内构建 |
人口腔癌细胞 | ATCC/ScienCell/中科院/复旦大学/国内构建 |
人口腔粘膜上皮细胞 | ATCC/ScienCell/中科院/复旦大学/国内构建 |
人卵巢癌紫杉醇耐药株 | ATCC/ScienCell/中科院/复旦大学/国内构建 |
人卵巢透明细胞癌细胞 | ATCC/ScienCell/中科院/复旦大学/国内构建 |
人脑胶质瘤细胞 | ATCC/ScienCell/中科院/复旦大学/国内构建 |
人脑神经胶质瘤细胞 | ATCC/ScienCell/中科院/复旦大学/国内构建 |
人脑微血管内皮细胞 | ATCC/ScienCell/中科院/复旦大学/国内构建 |
人膀胱癌组织细胞 | ATCC/ScienCell/中科院/复旦大学/国内构建 |
人膀胱上皮细胞 | ATCC/ScienCell/中科院/复旦大学/国内构建 |
人胚肾细胞(Sars结构蛋白基因修饰) | ATCC/ScienCell/中科院/复旦大学/国内构建 |
人胚胎成纤维细胞 | ATCC/ScienCell/中科院/复旦大学/国内构建 |
人胚胎干细胞 | ATCC/ScienCell/中科院/复旦大学/国内构建 |
人皮肤成纤维细胞 | ATCC/ScienCell/中科院/复旦大学/国内构建 |
人破骨细胞 | ATCC/ScienCell/中科院/复旦大学/国内构建 |
人脐带间充质干细胞 | ATCC/ScienCell/中科院/复旦大学/国内构建 |
人脐动脉平滑肌细胞 | ATCC/ScienCell/中科院/复旦大学/国内构建 |
人脐静脉内皮细胞 | ATCC/ScienCell/中科院/复旦大学/国内构建 |
人脐静脉血管内皮细胞 | ATCC/ScienCell/中科院/复旦大学/国内构建 |
人前列腺癌细胞 | ATCC/ScienCell/中科院/复旦大学/国内构建 |
人侵袭性脉络膜黑色素瘤细胞 | ATCC/ScienCell/中科院/复旦大学/国内构建 |
人乳腺癌阿霉素耐药细胞株 | ATCC/ScienCell/中科院/复旦大学/国内构建 |
人乳腺癌细胞 | ATCC/ScienCell/中科院/复旦大学/国内构建 |
人乳腺癌细胞系 | ATCC/ScienCell/中科院/复旦大学/国内构建 |
人软骨细胞 | ATCC/ScienCell/中科院/复旦大学/国内构建 |
人神经母细胞瘤细胞 | ATCC/ScienCell/中科院/复旦大学/国内构建 |
人肾透明细胞癌 | ATCC/ScienCell/中科院/复旦大学/国内构建 |
人十二指肠腺癌 | ATCC/ScienCell/中科院/复旦大学/国内构建 |
人食管癌细胞 | ATCC/ScienCell/中科院/复旦大学/国内构建 |
人食管平滑肌细胞 | ATCC/ScienCell/中科院/复旦大学/国内构建 |
人视网膜母细胞瘤 | ATCC/ScienCell/中科院/复旦大学/国内构建 |
人视网膜微血管内皮细胞 | ATCC/ScienCell/中科院/复旦大学/国内构建 |
人髓核细胞 | ATCC/ScienCell/中科院/复旦大学/国内构建 |
人髓母细胞瘤细胞 | ATCC/ScienCell/中科院/复旦大学/国内构建 |
人胎盘绒膜癌细胞 | ATCC/ScienCell/中科院/复旦大学/国内构建 |
人胎盘滋养层细胞 | ATCC/ScienCell/中科院/复旦大学/国内构建 |
人套细胞淋巴瘤细胞 | ATCC/ScienCell/中科院/复旦大学/国内构建 |
人外周血白细胞 | ATCC/ScienCell/中科院/复旦大学/国内构建 |
人胃癌细胞(未分化) | ATCC/ScienCell/中科院/复旦大学/国内构建 |
人小细胞肺癌肺转移细胞 | ATCC/ScienCell/中科院/复旦大学/国内构建 |
人心肌成纤维细胞 | ATCC/ScienCell/中科院/复旦大学/国内构建 |
人血管内皮细胞 | ATCC/ScienCell/中科院/复旦大学/国内构建 |
人牙龈成纤维细胞 | ATCC/ScienCell/中科院/复旦大学/国内构建 |
人牙周膜上皮细胞 | ATCC/ScienCell/中科院/复旦大学/国内构建 |
人胰岛β细胞 | ATCC/ScienCell/中科院/复旦大学/国内构建 |
人泡上皮癌 | ATCC/ScienCell/中科院/复旦大学/国内构建 |
人早幼粒急性白血病细胞 | ATCC/ScienCell/中科院/复旦大学/国内构建 |
人脂肪间充质干细胞 | ATCC/ScienCell/中科院/复旦大学/国内构建 |
人子宫颈癌细胞(GFP基因修饰) | ATCC/ScienCell/中科院/复旦大学/国内构建 |
人子宫内膜癌细胞 | ATCC/ScienCell/中科院/复旦大学/国内构建 |
乳腺癌细胞 | ATCC/ScienCell/中科院/复旦大学/国内构建 |
乳腺癌组织细胞 | ATCC/ScienCell/中科院/复旦大学/国内构建 |
神经胶质细胞 | ATCC/ScienCell/中科院/复旦大学/国内构建 |
神经母细胞瘤细胞 | ATCC/ScienCell/中科院/复旦大学/国内构建 |
神经星形胶质细胞 | ATCC/ScienCell/中科院/复旦大学/国内构建 |
神经元细胞 | ATCC/ScienCell/中科院/复旦大学/国内构建 |
肾实质细胞 | ATCC/ScienCell/中科院/复旦大学/国内构建 |
肾系膜细胞 | ATCC/ScienCell/中科院/复旦大学/国内构建 |
肾小球内皮细胞 | ATCC/ScienCell/中科院/复旦大学/国内构建 |
肾小球足细胞 | ATCC/ScienCell/中科院/复旦大学/国内构建 |
食管癌细胞 | ATCC/ScienCell/中科院/复旦大学/国内构建 |
视网膜神经节细胞 | ATCC/ScienCell/中科院/复旦大学/国内构建 |
视网膜微血管内皮细胞 | ATCC/ScienCell/中科院/复旦大学/国内构建 |
胎盘滋养层细胞 | ATCC/ScienCell/中科院/复旦大学/国内构建 |
外周血白细胞 | ATCC/ScienCell/中科院/复旦大学/国内构建 |
胃粘膜上皮细胞 | ATCC/ScienCell/中科院/复旦大学/国内构建 |
小脑颗粒细胞 | ATCC/ScienCell/中科院/复旦大学/国内构建 |
小鼠B淋巴细胞 | ATCC/ScienCell/中科院/复旦大学/国内构建 |
小鼠Lewis肺癌细胞 | ATCC/ScienCell/中科院/复旦大学/国内构建 |
小鼠T淋巴瘤细胞 | ATCC/ScienCell/中科院/复旦大学/国内构建 |
小鼠单核巨噬细胞 | ATCC/ScienCell/中科院/复旦大学/国内构建 |
小鼠肺泡巨噬细胞 | ATCC/ScienCell/中科院/复旦大学/国内构建 |
小鼠肺微血管内皮细胞 | ATCC/ScienCell/中科院/复旦大学/国内构建 |
小鼠肝窦内皮细胞 | ATCC/ScienCell/中科院/复旦大学/国内构建 |
小鼠肝实质细胞 | ATCC/ScienCell/中科院/复旦大学/国内构建 |
小鼠骨骼肌细胞 | ATCC/ScienCell/中科院/复旦大学/国内构建 |
小鼠间充质干细胞 | ATCC/ScienCell/中科院/复旦大学/国内构建 |
小鼠海马神经元细胞 | ATCC/ScienCell/中科院/复旦大学/国内构建 |
小鼠巨噬细胞 | ATCC/ScienCell/中科院/复旦大学/国内构建 |
小鼠卵巢颗粒细胞 | ATCC/ScienCell/中科院/复旦大学/国内构建 |
小鼠胚胎成纤维细胞 | ATCC/ScienCell/中科院/复旦大学/国内构建 |
小鼠胚胎干细胞 | ATCC/ScienCell/中科院/复旦大学/国内构建 |
小鼠肾足细胞 | ATCC/ScienCell/中科院/复旦大学/国内构建 |
小鼠胃癌细胞 | ATCC/ScienCell/中科院/复旦大学/国内构建 |
小鼠心肌细胞 | ATCC/ScienCell/中科院/复旦大学/国内构建 |
小鼠星形胶质细胞 | ATCC/ScienCell/中科院/复旦大学/国内构建 |
小鼠成纤维细胞 | ATCC/ScienCell/中科院/复旦大学/国内构建 |
小鼠主动脉平滑肌细胞 | ATCC/ScienCell/中科院/复旦大学/国内构建 |
小鼠子宫内膜上皮细胞 | ATCC/ScienCell/中科院/复旦大学/国内构建 |
小细胞肺癌细胞 | ATCC/ScienCell/中科院/复旦大学/国内构建 |
心房肌细胞 | ATCC/ScienCell/中科院/复旦大学/国内构建 |
心肌成纤维细胞 | ATCC/ScienCell/中科院/复旦大学/国内构建 |
心肌细胞 | ATCC/ScienCell/中科院/复旦大学/国内构建 |
心脏微血管内皮细胞 | ATCC/ScienCell/中科院/复旦大学/国内构建 |
星形胶质细胞--中脑 | ATCC/ScienCell/中科院/复旦大学/国内构建 |
雪旺氏细胞 | ATCC/ScienCell/中科院/复旦大学/国内构建 |
血管平滑肌细胞 | ATCC/ScienCell/中科院/复旦大学/国内构建 |
牙龈上皮细胞 | ATCC/ScienCell/中科院/复旦大学/国内构建 |
胰岛β细胞 | ATCC/ScienCell/中科院/复旦大学/国内构建 |
诱导性多能干细胞 | ATCC/ScienCell/中科院/复旦大学/国内构建 |
杂交瘤细胞 | ATCC/ScienCell/中科院/复旦大学/国内构建 |
正常肝细胞 | ATCC/ScienCell/中科院/ |
|
|
上海栩冉生物科技有限公司!您科研路上的好帮手!